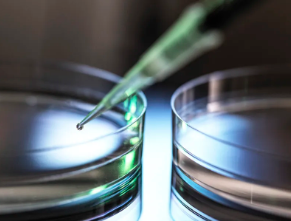
image.png

中國幹細胞療法進展情況如何,有什麽突破
2024-11-16 15:00:39 來源: 小編 咨詢醫生
本文将深入探讨我國幹細胞療法的研究現狀、取得的突破性成果以及未來的發展方向。
近年來,幹細胞療法作爲一種新興的生物治療方法,在我國得到了廣泛的關注和研究。以下是關于中國幹細胞療法的進展情況和突破性成果的詳細介紹。
一、研究現狀
我國在幹細胞療法領域的研究已經取得了顯著成果,不僅在基礎研究方面取得了突破,還在臨床應用方面取得了重要進展。目前,我國幹細胞療法的研究主要集中在以下幾個方面:
1.幹細胞來源的拓展:研究者們不斷探索新的幹細胞來源,包括胚胎幹細胞、成體幹細胞、誘導多能幹細胞等,以滿足臨床應用的需求。
2.幹細胞定向分化:通過基因編輯、生長因子調控等手段,使幹細胞定向分化爲所需的功能細胞,用于修複受損組織或器官。
3.幹細胞移植與再生醫學:将幹細胞移植到患者體内,促進組織修複和器官再生,治療各類疾病。
二、突破性成果
1.成體幹細胞治療心髒病:我國科學家利用成體幹細胞治療心髒病取得了重要突破。通過将成體幹細胞注射到患者心髒,使其分化爲心肌細胞,從而修複受損的心肌組織,改善心髒功能。
2.誘導多能幹細胞治療神經退行性疾病:我國研究人員利用誘導多能幹細胞技術,成功制備出神經元樣細胞,用于治療帕金森病、阿爾茨海默病等神經退行性疾病。
3.幹細胞治療皮膚損傷:我國研究者利用幹細胞技術,成功制備出人工皮膚,用于修複皮膚損傷,爲燒傷、創傷等患者帶來福音。
4.幹細胞治療血液病:我國在幹細胞治療血液病方面取得了顯著成果,如利用幹細胞移植技術治療白血病、再生障礙性貧血等疾病。
三、未來發展方向
1.加強基礎研究:繼續探索幹細胞的生物學特性,揭示其分化、移植和修複機制,爲臨床應用提供理論基礎。
2.優化幹細胞制備技術:提高幹細胞的制備效率和純度,降低制備成本,爲臨床應用提供高質量的幹細胞。
3.開展多中心臨床試驗:加強臨床試驗的規範化和标準化,提高臨床試驗的可靠性和有效性。
4.加強國際合作與交流:與國際先進水平接軌,共同推動幹細胞療法的發展。
總之,我國幹細胞療法在研究現狀、突破性成果和未來發展方向方面都取得了顯著成果。相信在不久的将來,幹細胞療法将爲更多患者帶來福音。
-
下一頁: 幹細胞和肽哪個效果好點,如何選擇更适合的
- 2024-10-22中檢院認證的幹細胞機構名單有哪些
- 2024-11-01生殖幹細胞作用機制如何?其研究進展有哪些突破?
- 2024-10-28造血幹細胞捐獻後如何恢複身體?捐獻造血幹細胞有哪些影響?
- 2024-07-24異基因造血幹細胞移植,異基因造血幹細胞移植要多少錢
- 2024-10-25安然蟲草幹細胞作用有哪些?副作用是什麽?
- 2024-11-06幹細胞治療視神經如何操作?如何選擇幹細胞治療技術?
- 2024-09-11幹細胞治療最新研究進展,幹細胞治療的前景和現狀
- 2024-07-24幹細胞治療腫瘤,幹細胞抗癌的作用和功效
- 2024-10-11什麽因素影響幹細胞回輸成本?怎樣選擇性價比高的服務?
- 2024-09-07造血幹細胞移植後食譜及注意事項
- 2024-09-10幹細胞填淚溝效果好嗎,能維持多久
- 2024-08-09幹細胞療法治療腰突有希望嗎
- 2024-09-12肝硬化幹細胞移植醫院排名榜
- 2024-08-06打一針幹細胞要多少錢,打一針幹細胞能管幾年
- 2024-09-06廣東牙髓幹細胞功效及臨床應用
- 2024-10-08幹細胞對皮膚具體有哪些作用,效果如何顯著
- 2024-08-21幹細胞療法高血脂能治好嗎,治療原理及效果介紹
- 2024-08-01幹細胞美容效果,幹細胞美容有什麽副作用
